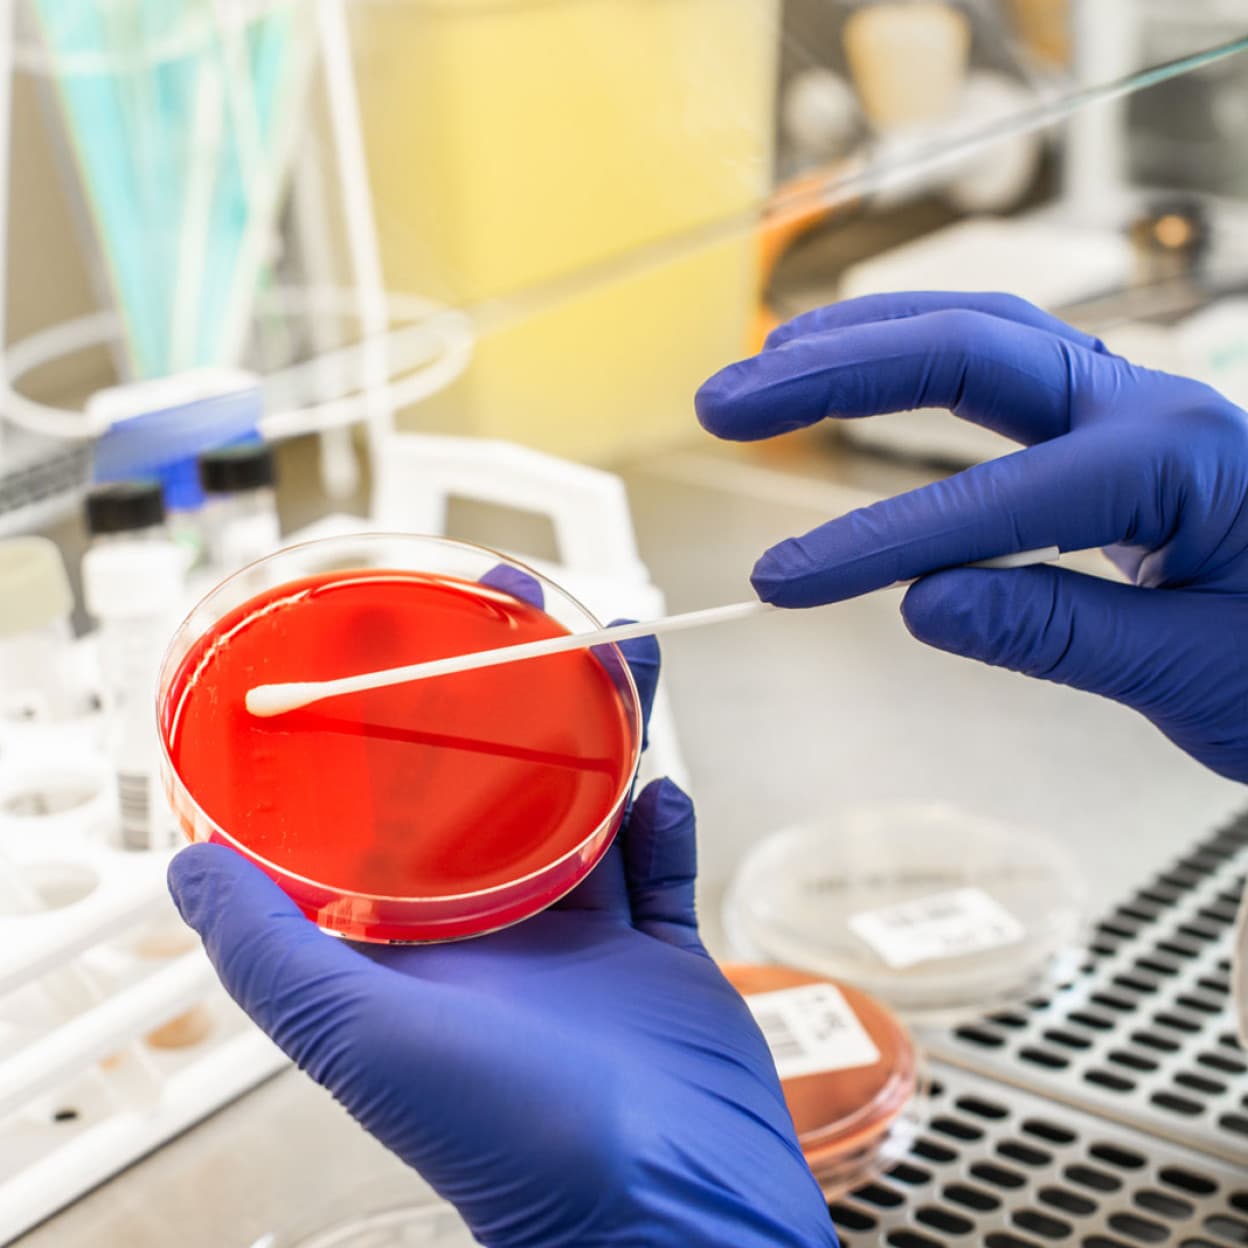

Radiologie Bregenz
Radiologietechnologie ist ein riesiges Arbeitsfeld. An unserem Standort in Bregenz zeigen wir dir, woran wir mit welchen Methoden arbeiten.
Kontakt
- Ansprechpartnerin
- Bernadette Hörburger
- Telefon
- +43 5574 401 4203
Wir öffnen unsere Türen für euch: Meldet euch zu einer Führung oder einem Schnuppertag an und erhaltet einen direkten Einblick in die Arbeit der Gesundheitsprofis in der Radiologie oder im Labor.

Die Gesundheitsprofis bieten zweistündige Führungen für Schulklassen oder einzelne Schüler:innen an. Besichtigt werden können: die Abteilung für Radiologie am LKH Bregenz und das Medizinische Zentrallabor in Feldkirch Dabei wird das Berufsbild kurz vorgestellt, danach gibt es eine Führung durch die Abteilung und zum Schluss noch Informationen zur Ausbildung.
Mit verschiedenen bildgebende Methoden wie Röntgen, Computertomografie, Ultraschall oder Magnetresonanztomografie machen Radiologietechnologinnen und -technologen Bilder vom Körper. Diese Bilder werden, zusammen mit Ärztinnen und Ärzten, ausgewertet und dienen der Diagnostik. In der Radiologie gibt es aber auch aktive Behandlungsmethoden um Gewebeproben zu untersuchen, Gefäße zu öffnen oder Blutungen zu stillen. Ganz schön abwechslungsreich.
Die zweistündige Führung findet regulär am LKH Bregenz statt. Auf speziellen Wunsch sind auch Führungen in der Radiologie am LKH Feldkirch möglich.

Ohne Biomedizinische Analytiker:innen würden viele Krankheiten unentdeckt bleiben oder wären gar nicht erst in Büchern beschrieben. Damit das nicht passiert, werden Blutproben, Gewebe und Zellen ins Labor gebracht und von Profis untersucht. Biomedizinische Analytiker:innen kultivieren zum Beispiel auch Mikroorganismen und finden so heraus, welches Antibiotikum in der Therapie helfen kann. Hier gibt es viel zu sehen!
Beide Führungen finden am LKH Feldkirch in der jeweiligen Abteilung statt.
Du kannst dir vorstellen, Biomedizinische Analytik oder Radiologietechnologie zu studieren? Dann kannst du dir bei einem Schnuppertag am LKH Feldkirch oder Bregenz oder im Medizinischen Zentrallabor in Feldkirch ein gutes Bild von deinem möglichen Berufsalltag machen.
Radiologietechnologie ist ein riesiges Arbeitsfeld. An unserem Standort in Bregenz zeigen wir dir, woran wir mit welchen Methoden arbeiten.
Das Strahlenzentrum am LKH Feldkirch zählt zu den modernsten Europas! Komm vorbei und überzeug dich selbst.
Im MZL werden rund 500 verschiedene Laboruntersuchungen gemacht. Was genau dahintersteckt, erfährst du vor Ort. Spoiler: Es wird nicht nur Blut untersucht.
Pathologie ist viel mehr als das, was du aus Krimis kennst. Wir zeigen dir, wie wir Ärzt:innen bei der Diagnose und Auswahl der geeigneten Therapie unterstützen.

